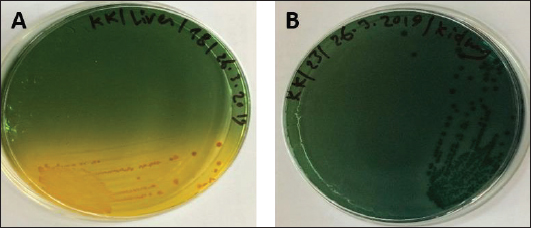

| Original Article | ||
Open Vet. J.. 2023; 13(3): 327-336 Open Veterinary Journal, (2023), Vol. 13(3): 327–336 Original Research Pathological lesions associated with Vibrio infection in Atlantic horse mackerel (Trachurus trachurus L., 1758) from the western coast of Tripoli, LibyaKhawla K. Bukha1, Shaima A. M. Mahgiubi2, Asma M. Elbahi3, Ehab A. Sharif1, Mohamed L. Showehdi1, Mohamed O. Ahmed4, Abdulwahab M. Kammon1,5, and Yousef M. Abouzeed4*1Department of Poultry and Fish Diseases, Faculty of Veterinary Medicine, University of Tripoli, Tripoli, Libya 2Department of Pathology and Clinical Pathology, Faculty of Veterinary Medicine, University of Tripoli, Tripoli, Libya 3Department of Anatomy, Histology and Embryology, Faculty of Veterinary Medicine, University of Tripoli, Tripoli, Libya 4Department of Microbiology and Parasitology, Faculty of Veterinary Medicine, University of Tripoli, Tripoli, Libya 5National Research Center for Tropical and Transboundary Diseases, Alzintan, Libya *Corresponding Author: Yousef M. Abouzeed. Department of Microbiology and Parasitology, Faculty of Veterinary Medicine, University of Tripoli, Tripoli, Libya. Email: y.abouzeed [at] uot.edu.ly. Submitted: 17/07/2022 Accepted: 22/02/2023 Published: 14/03/2023 © 2023 Open Veterinary Journal
AbstractBackground: Vibrios are aquatic bacteria causing Vibriosis in humans and aquatic animals. Vibriosis is a significant disease of cultured and wild fish. Aim: The present study aimed to address the impact of Vibrios on the health status of Trachurus trachurus inhabiting the coastal area of Tripoli. Methods: A total of 100 samples of (T. trachurus) were collected randomly from the Western Coast of Tripoli and Bab Al-Baher market, throughout the period from spring 2019 to summer 2019. All the sampled fish were examined externally and internally and lesions were recorded. Bacterial isolation from the liver and kidney was carried out using the appropriate culture media. Tissue samples were taken from the liver, kidney, and spleen in 10% neutral buffered formalin for a histopathology examination. The tissue sections were stained with hematoxylin and eosin to assess morphologically and Perl's Prussian blue for the demonstration of ferric iron. Results: On average 69% of the infected fish exhibited at least one pathological lesion. Vibrios were recovered from 90% of the examined fish. The histopathological changes of the liver showed severe congestion of blood vessels (BVs), mononuclear cell infiltration surrounding a bile duct, granular degeneration and coagulative necrosis of hepatocytes in the centrilobular area, marked vacuolar degeneration of hepatocytes, activation of melano-macrophage centers (MMCs), multiple cysts of nematode in hepatic tissue (incidental finding). The histopathological alterations of the kidney showed severe congestion of BVs, vacuolar degeneration of the renal tubular epithelium, severe interstitial mononuclear cell infiltration, and marked activation of MMCs in the kidney. Moreover, congestion of BVs and marked activation of melano-macrophages (MMCs) were found in the spleen. The MMCs of most of the sampled tissues showed a strong positive reaction for ferric iron. Conclusion: The polluted aquatic environment by sewage at Tripoli Coast is an essential factor for triggering the pathogenicity and invasion of Vibrios to vulnerable Atlantic horse mackerel. Also, this study is a preliminary step to give a baseline for further future studies on epidemiology and control of Vibrio infection in Libyan fish. Keywords: Atlantic horse mackerel, Vibrionaceae, Histopathological changes, Melano-macrophages centers. IntroductionGlobally, there is an increase in diseases associated with Vibrios that has a great impact on marine animals and humans (Roux et al., 2015). Vibrios are aquatic bacteria and ubiquitous in the marine environment causing Vibriosis in aquatic animals and humans (de Souza Valente and Wan, 2021). It is considered a serious problem with severe economic losses worldwide. Symptoms of Vibriosis in fish include anemia, ascites fluid, intestinal necrosis, petechial hemorrhages in the muscle wall, and liquid in the air bladder (El-Sharaby et al., 2018). Vibriosis is considered a very important zoonotic disease. Vibrio infection in humans is associated with clinical symptoms like gastroenteritis or primary septicemia due to the consumption of raw or undercooked contaminated seafood. It can cause death in aquatic animals and humans (Helmi et al., 2020; de Souza Valente and Wan, 2021). Every year, Vibriosis causes 80,000 diseases and 100 deaths in the United States (Newton et al., 2012). Seafood has become a very important source of protein in the humans diet in recent years because it contains all essential amino acids and is easier to digest than animal protein (Balami et al., 2019). The Carangidae family has about 25 genera and 200 species (El Achi et al., 2021). Atlantic horse mackerel fish belongs to the large carangidae “perciforms” family (Carbonara et al., 2012). The genus Trachurus has three species: Trachurus trachurus, Trachurus mediterraneus and Trachurus picturatus. Most of the species are predators “pelagic feeders” that predate on planktonic organisms (Erdogan et al., 2016). Atlantic horse mackerel is a popular commercial fish in public markets. It is very popular for consumers in Turkey, Spain, and North African countries, having an annual catching value of 12,213.2 tons (Ab Rahman et al., 2015; Tosun et al., 2016; Balami et al., 2019). Moreover, it is considered a migratory fish species that is indigenous to the Mediterranean, and Black Sea (Abaunza et al., 2008; Aksissou and Casal, 2013). Recently, the interaction between animal health, human health, and environmental health have been recognized as one health (OH) concept (Bukha et al., 2022). OH concept is the incorporation of the direct impact of the environment on animal and human health (Bonilla-Aldana et al., 2020; Jorwal et al., 2020). Therefore, the quality of the marine ecosystem is essential for maintaining human health (Rahman et al., 2020). The Mediterranean and Black Sea fisheries are threatened by the effects of increased pollution from human activities. Several Mediterranean countries are dumping their sewage into the seashores without treatment (FAO, 2016). However, Sewage can be loaded with pathogenic microorganisms that can seriously contaminate coastal waters. This microorganism can be taken up by fish, shellfish, and other aquatic organisms, thus increasing the possibility of their entry into the food chain of fish (Zutshi and Prasad, 2008; FAO, 2016). Globally, Vibrio infection is a threat to public health, which is related to fisheries. Difficulty in minimizing the spread of Vibriosis due to the widespread of the Vibrios and its high ability to persist in the aquatic environment (Osunla and Okoh, 2017). In Libya, there is no previous data about the detection of Vibrios affecting Atlantic horse mackerel. Thus, the current study was designed to address the impact of Vibrios on the health status of highly commercial Atlantic horse mackerel (T. trachurus) inhabiting the Western Coast of Tripoli, Libya and describe the possible pathological lesions that might be associated with Vibrio infection. Finally, to underline the risk that may pose to public health. Material and MethodsFish samplingA total of 100 samples of Atlantic horse mackerel (T. trachurus) were collected randomly from the Western Coast of Tripoli and Bab Al-Baher market, throughout the period from spring 2019 to summer 2019. A total of 50 samples were collected seasonally, 40 fresh fish were collected directly from the fisherman on the boat after catching, and 10 fish were collected from Bab-Albahr market. Fish samples were kept on crushed ice in an insulated icebox and transferred to the Laboratory of Poultry and Fish Diseases, Faculty of Veterinary Medicine, University of Tripoli, Tripoli, Libya. Sample processingFish were flushed with ethanol 70% to get rid of external contaminants. Using the three-line technique (Triangular incision) fish were cut open from the left side to expose internal organs. Fish were externally and internally examined for any possible lesions which were photographed using a digital camera (Sony, Japan). Bacterial isolationThe modified protocol by Austin et al. (2012) was used for bacterial isolation. After clinical examination of the samples, liver, and kidney materials were inoculated onto alkaline peptone water (APW) tubes supplemented with 2% NaCl and incubated at 25°C–27°C for 24 hours. Aliquots from inoculated APW tubes were streaked onto modified Thiocitrate Bile Salt Sucrose Agar (TCBS) and onto MacConkey agar (Oxoid, UK). Each media was supplemented with 1%–2% NaCl. The inoculated plates were then incubated at 25°C–27°C for 24–72 hours at maximum. The plates were inspected for any possible colonial growth. The culture characteristics of the retrieved colonies were recorded. Morpho-chemical characterizations were performed using conventional biochemical tests (Gram stain, oxidase, and catalase). Histopathological examinationTissue specimens were taken from the affected organs (liver, kidney, and spleen) and were fixed in 10% buffered formalin for later processing and examination, according to Bancroft and Gamble (2008). The stained tissue sections hematoxylin and eosin (H&E) and Perl's Prussian blue stain were examined under the light microscope (ZEISS, Germany). ResultsClinical findingsMost of the macroscopical examined fish exhibited typical signs of septicemic diseases including hemorrhagic patches on different areas on the surface of fish and the base of the fins, ascites, and congestion of internal organs. On average 69% of the infected fish exhibited at least one lesion. The external lesions during the spring and summer seasons were hemorrhages at the base of the pectoral fin and around the operculum, congestion of pelvic, caudal, and anal fins (Fig. 1a and b). While internal lesions were splenomegaly, pale liver, congested liver, hemorrhagic liver, kidney, and swim bladder (Fig. 1c–e). Percentages of sampled fish with external lesions from the spring to the summerDuring the spring season, a high percentage of the fish showed hemorrhage at the base pectoral fin 22%, and just 3% exhibited congested caudal fin 3% (Fig. 2). However, during the summer season, a high percentage of the fish showed hemorrhage around the operculum 38%, and only 2% showed dark pigmentation patches on the skin (Fig. 3).
Fig. 1. Atlantic horse mackerel naturally infected with Vibrio species showing: (a) congestion of caudal fine (white arrow) and anal fin (black arrow). (b) Hemorrhage at the base of pectoral fin (black arrow) and arund the operculum (white arrow) in addition to congestion of pelvic fin (asterisk). (c) Congested liver (white arrow), mild hemorrhage in swim bladder (black arrow), severe hemorrhage in kidney (white arrow), and splenomegaly. (d) Pale liver (white arrow). (e) Severe hemorrhagic liver (white arrow) and kidney (black arrow). Percentages of sampled fish with internal lesions from the spring to the summerDuring the spring season, a high percentage of the fish showed pale liver 20%, but only 6% of the fish showed hemorrhage on all internal organs (Fig. 4). Whereas, during the summer season 20% of the fish showed pale liver and 2% splenomegaly (Fig. 5). Bacteriological examinationMorphological, culture characters, and biochemical identification On modified TCBS medium the retrieved colonies appeared as circular yellow or green colonies ranging from pinpoint to 2–3 mm characteristic of Vibrio spp. (Fig. 6a and b). On the MacConkey medium the retrieved colonies were circular colorless colonies ranging from pinpoint to 2 mm (Non-lactose fermenting), and circular dark pink colonies (Lactose fermenting) (Fig. 7a and b). Bacteria were Gram-negative curved rods, oxidase, and catalase-positive. Prevalence of Vibrio retrieved Vibrio isolates from sampled fish The data revealed that Vibrios was recovered from 90% (90/100) of the examined fish during two samplings (spring and summer) (Fig. 8). While the prevalence of Vibrio isolates that were isolated from examined fish obtained from the Bab Albahr fish market was 100% during summer and 60% during the spring season (Fig. 9). Histopathological examination Histopathological examination of kidney tissue of Atlantic horse mackerel naturally infected with Vibrio species showed severe congestion of blood vessels (BVs), vacuolar degeneration of the renal tubular epithelium, severe interstitial mononuclear cell infiltration, and marked activation of melano-macrophages centers (MMCs) (Fig. 10a and b). While examination of the spleen revealed severe congestion of BVs and marked activation of MMCs (Fig. 10c). Histopathological examination of liver tissue exhibited severe congestion of BVs, mononuclear cell infiltration of portal triads and hyperplasia of the bile duct (Fig. 11a and b). The hepatocytes showed degenerative changes in the form of granular and vacuolar degeneration in addition to coagulative necrosis (Fig. 11c and d). Mild activation of MMCs was also seen (Fig. 11e). In some hepatic tissue, multiple cysts of nematode were observed (incidental finding) (Fig. 11f). The MMCs of most of the sampled tissues showed a strong positive reaction for ferric iron (Fig. 12). DiscussionFish health problems mainly are related to aquatic environmental stress. However, any disease conditions are the outcome of the interaction between three dynamic factors: pathogen, susceptible host, and environmental stress (Austin 2011; Austin et al., 2012; Rehman et al., 2015; Eissa et al., 2017). Many Mediterranean countries are directly dumping their municipal sewage into seashore without any treatments (Eissa et al., 2015). Moreover, untreated wastewater can possibly transfer zoonotic pathogens from land to the sea, leading to increasing the possibility of entering pathogenic organisms into the food chain of fish (Eissa et al., 2015, 2017). Several bacterial infections of public health concerns such as Vibriosis, Mycobacteriosis, and streptococcosis have been reported in many fishes of the Mediterranean Basin. These pathogenic bacteria are usually associated with food-borne illnesses through consumption of insufficiently cooked fish (Eissa et al., 2015). Vibrios are critically serious pathogens that can cause fatal diseases in aquatic animals and humans.
Fig. 2. Percentages of sampled fish with external lesions during spring season.
Fig. 3. Percentages of sampled fish with external lesions during summer season.
Fig. 4. Percentages of samped fish with internal lesions during spring seaseon.
Fig. 5. Percentages of sampled fish with internal lesions during summer season.
Fig. 6. (A) Modified TCBS sucrose agar culture plate showing the yellow colonies of Vibrio isolates and (B) TCBS culture showing the green colonies of Vibrio isolates.
Fig. 7. (A) MacConkey culture plate showing circular colorles colonies of Vibrio isolates (Non- lactose fermenting) and (B) MacConeky culture plate showing circular pink colonies of Vibrio isolates (lactose fermenting).
Fig. 8. Prcentages of total retrivied Vibrio isolates from sampled fish.
Fig. 9. Percentages of retrivied Vibrio isolates from sampled fish obtained from Bab-Albahr market collected during spring and summer of 2019. In this study, high percentages of Atlantic horse mackerel with several external pathological lesions have been found during the spring and summer of 2019. Whereas, the numbers of fish samples without pathological lesions were quite low. Interestingly, our data revealed that around 69% of the examined Atlantic horse mackerel collected from the Western Coast of Tripoli, Libya have shown typical signs (lesions) of severe Vibrio infection which is coincided with bacteriological results. Our results are consistently in accord with results obtained by Mohamad et al. (2019) have reported 60% of the examined fish that showed pale and hemorrhagic livers, hemorrhagic kidneys, ulcerative lesions, and focal hemorrhages. Furthermore, the examined fish that showed one or more pathological lesions also had a positive culture for Vibrio species. Also, this is in accordance with previous findings observed by Boran et al. (2013) who have found hemorrhage on the liver, enlarged spleen and dark pigmentation, ascities, and petechial hemorrhage on the abdomen of examined horse mackerel. Some of the examined horse mackerel in the current study were considered apparently normal nonetheless their culture results were positive for Vibrio spp. Moreover, Eissa et al. (2017) reported higher percentages of the examined common panadora (Pagellus erythrinus) from the coast of Tripoli were apparently normal yet they were positive for Vibrio spp., these findings are totally concurred with the results of the current study.
Fig. 10. Histopathological findings in the kidney and spleen of Atlantic horse mackerel naturally infected with Vibrio species. (a and b) Kidney showing severe congestion of BVs (asterisk), vacuolar degeneration of the renal tubular epithelium (white arrows), severe interstitial mononuclear cell infiltration (black arrows) and marked activation of MMCs. (c) Spleen showing congestion of BVs (black arrows) and marked activation of MMCs (H&E stain: a and c ×20; b × 40). The present study has revealed that the prevalence of Vibrio in examined Atlantic horse mackerel was 90% (90/100) during the study period, spring and summer season of 2019. However, nearly similar results were reported by Tan et al. (2017) who have found a high prevalence of 89.2% (116/130) of Vibrio in mackerel fish. The study of El-Sharaby et al. (2018) revealed that Vibrio spp. was successfully recovered from 39% of examined fish collected from the Delta region, Egypt, this is agree with the results of the current study. The discrepancy in results between previous studies and the study herein can be attributed to many factors including the sample size, species of the fish, water quality, season, and area of collection. Our study is in accordance with other studies investigated Vibrio spp. infection in different fish species from the Libyan Coasts (Madi et al., 2006; Elshrif et al., 2007; Madi et al., 2015a, 2015b). To the best of our knowledge, this is the first report on isolation of Vibrio spp. from T. trachurus from Tripoli Coast. Our results revealed that the prevalence of Vibrio isolates from examined Atlantic horse mackerel obtained from the Bab Albahr market was 100% during summer. Our results fall within the range reported by Tan et al. (2017) where the prevalence of Vibrio in horse mackerels from wet markets was (97%) followed by minimarkets (89.1%) and hypermarkets (83.3%). Our findings are also in agreement with the study of Bakr et al. (2011) who determined the presence of Vibrios in 52% of samples obtained from different markets in Alexandria. Vibrio infected Atlantic horse mackerel examined herein concurrently showed notable histopathological changes with marked activation of MMCs. Furthermore, the presence of hemosiderin in MMC has been demonstrated by Perl's Prussian blue stain and confirmed that phagocytic melanocytes accurately dependent on iron content, which is produced during the deterioration of red blood cells in response to immune system activation and possibly lead to MMC formation (Handy and Penrice, 1993).
Fig. 11. Histopathological findings in the liver of Atlantic horse mackerel naturall infected with Vibrio species. Photomicrographs showing (a) severe congestion of BV; (b) mononuclear cell infiltration surrounding a bile duct (white arrows); (c) granular degenration (white arrows) and coagulative necrosis (black arrows) of hepatocytes in centrilobular area; (d) marked vacuolar degeneration of hepatocytes (black arrows); (e) activation of MMCs; and (f) multiple cysts of nematode in the hepatic tissue (black arrows) (incidental finding) (H&E stain: a, e, and f × 10; c × 20; b and d × 40).
Fig. 12. Histological section of liver of Atlantic horse mackerel showing positive staining reaction for hemosiderin (black arrows) (Perl's Prussian blue stain, ×20). The results of histopathological examination are in accordance with the previous study of Eissa et al. (2015) that revealed the presence of severe renal tubular degeneration and necrosis of renal tubular in the kidney, severe MMC activation in the splenic tissue sections, and focal necrosis of hepatic tissue, and severe vacuolar degeneration of hepatic cords in the liver sections. The histopathological changes were less prominent in bacteriological negative culture specimens. The appearance of histopathological lesions on the organs of T. trachurus refers to the septicemia nature of Vibriosis infection. In addition, these lesions confirm our hypothesis that the biological pollutants in swage hold many pathogenic bacteria and parasites which can seriously contaminate coastal waters. These pathogens can be taken up by zooplanktons as shellfishes, thus increasing the possibility of their entry into the food chain of the fish. During spawning season, Atlantic horse mackerel approaches the coastal area where it feeds on these contaminated crustaceans. This can really compromise the immunity of the fish and increases the likelihood of bacterial and parasitic infection which will eventually enter the human food chain. In our study, nematodes larvae were observed in some histological sections of the liver (incidental findings). Interestingly, there were no host inflammatory reactions seen in these sections. Several studies have been conducted on different types of fish from the coast of Tripoli, and revealed that there is an aquatic model of Nematode/Vibrio concurrent infection in the examined fish, this is consistent with our findings (Eissa et al., 2017, 2018). ConclusionThe isolation of Vibrios, finding nematodes larvae, and high numbers of MMCs in histological sections are highly indicative of the deteriorated seawater quality and clear evidence of sewage contamination of the coastal area of Tripoli-Libya. An ongoing dynamic problem caused by the random dumping of untreated municipal sewage into the marine environment can adversely affect fish and human health. Vibrio infection within Libyan fishes has not been widely studied with many gaps in these studies. Therefore, these gaps need to be more studied in future research. AcknowledgmentThis study was part of the Master Dissertation of Khawla Khirallah Bukha titled “Study on pathological changes associated with Gram-negative bacteria in Atlantic horse mackerel T. trachurus from the central coast of Tripoli”. Conflicts of interestThe authors declare that they have no conflict of interest ReferencesAb Rahman, N., Chowdhury, A.J.K., Abidin, Z. and Azira, Z. 2015. Antibiotic resistant bacteria from sediment of coastal water of pahang, Malaysia. J. Teknol. 77(24), 65–70. Abaunza, P., Murta, A.G., Campbell, N., Cimmaruta, R., Comesaña, A., Dahle, G., Santamaria, M., Gordo, L., Iversen, S., Mackenzie, K., Magoulas, A., Mattiucci, S., Molloy, J., Nascetti, G., Pinto, A.L., Quinta, R., Ramos, P., Sanjuan, A., Santos, A.T. and Zimmermann, C. 2008. Stock identity of horse mackerel (Trachurus trachurus) in the northeast Atlantic and Mediterranean sea: integrating the results from different stock identification approaches. Fish. Res. 89, 196–209. Aksissou, M. and Casal, J.A.H. 2013. Age and growth of the horse mackerel Trachurus trachurus (Linnaeus, 1758) catches in the bay of m’diq (Mediterraneen coast of Morocco). IRACST Eng. Sci. Technol. Int. J. 3(4), 708–714. Austin, B. 2011. Taxonomy of bacterial fish pathogens. Vet. Res. 42(1), 20. Austin, B., Austin, D.A., Austin, B. and Austin, D.A. 2012. Bacterial fish pathogens. Cham, Switzerland: Springer. Bakr, W.M., Hazzah, W.A. and Abaza, A.F. 2011. Detection of Salmonella and Vibrio species in some seafood in Alexandria. J. Am. Sci. 7(9), 663–668. Balami, S., Sharma, A. and Karn, R. 2019. Significance of nutritional value of fish for human health. Malaysian. J. Halal. Res. J. 2(2), 32–34. Bancroft, J.D. and Gamble, M. 2008. Theory and practice of histological techniques. Amsterdam, The Netherlands,: Elsevier Health Sciences. Bonilla-Aldana, D.K., Holguin-Rivera, Y., Perez-Vargas, S., Trejos-Mendoza, A.E., Balbin-Ramon, G.J., Dhama, K., Barato, P., Lujan-Vega, C. and Rodriguez-Morales, A.J. 2020. Importance of the one health approach to study the SARS-COV-2 in Latin America. One Health. 10, 100147. Boran, H., Terzi, E., Altinok, I., Capkin, E. and Bascinar, N. 2013. Bacterial diseases of cultured mediterranean horse mackerel (Trachurus mediterraneus) in sea cages. Aquaculture 396, 8–13. Bukha, K.K., Sharif, E.A. and Eldaghayes, I.M. 2022. The one health concept for the threat of severe acute respiratory syndrome coronavirus-2 to marine ecosystems. Int. J. One. Health. 8(1) 48–57. Carbonara, P., Casciaro, L., Bitetto, I. and Spedicato, M. 2012. Reproductive cycle and length at first maturity of Trachurus trachurus in the central-western mediterranean seas/ciclo riproduttivo e taglia di prima maturitá di Trachurus trachurus nei mari del mediterraneo centro-occidentale. Biologia. Marina. Mediterranea. 19(1), 204. de Souza Valente, C. and Wan, A.H. 2021. Vibrio and major commercially important vibriosis diseases in decapod crustaceans. J. Inverteb. Pathol. 181, 107527. Eissa, A.E., Abdelsalam, M., Abumhara, A., Kammon, A., Gammoudi, F.T., Ben Naser, K.M., Borhan, T. and Asheg, A. 2015. First record of Vibrio vulnificus/anisakis pegreffi concurrent infection in black scorpionfish (Scorpaena porcus) from the south Mediterranean basin. Res. J. Pharma. Biol. Chem. Sci. 6(3), 1537–1548. Eissa, A.E., Altakaly, M.B., Abolghait, S.K., Ismail, M.M. and Abumhara, A. 2017. Detection of the most common Vibrios affecting common pandora (Pagellus erythinus) from the coasts of Tripoli, Libya. J. Fish. Aquat. Sci. 12, 253–263. Eissa, A.E., Showehdi, M.L., Ismail, M.M., El-Naas, A.S., Mhara, A.A.A. and Abolghait, S.K. 2018. Identification and prevalence of Anisakis pegreffii and A. Pegreffii× A. Simplex (ss) hybrid genotype larvae in atlantic horse mackerel (Trachurus trachurus) from some North African Mediterranean coasts. Egypt. J. Aquat. Res. 44(1), 21–27. El-Sharaby, S., Abd-Elgaber, M., Tarabees, R., Khalil, R., Ali, M. and El-Ballal, S. 2018. Bacteriological and histopathological studies on Vibrio species isolated from naturally infected freshwater fish in delta region, Egypt. Adv. Anim. Vet. Sci. 6(1), 17–26. El Achi, A., Nafia, M., Manchih, K., Baali, A. and Moncef. M. 2021. Reproductive biology of horse mackerel Trachurus trachurus (Linnaeus, 1758) in the North Atlantic Moroccan coast. Egypt. J. Aquat. Biol. Fish. 25(3), 647–666. Elshrif, E.A., Elmarghani, A.M., Zweki, M.B., Elshewhdy, M.A. and Giddafi, M.H. 2007. The level of bacterial pollution associated with discharge of untreated sewage into the sea for cities of Misurata and Alkhums. Tripoli, Libya: Marine Biology Research Center. Erdogan, Z., Torcu Koc, H., Ulunehir, G. and Joksimovic, A. 2016. Some biological properties of different populations of the Atlantic horse mackerel Trachurus trachurus (l.) in Turkish seas. Acta. Adriatica. 57(1), 51–62. FAO. 2016. The state of mediterranean and black sea fisheries. Rome, Italy: FAO. Handy, R. and Penrice, W. 1993. The influence of high oral doses of mercuric chloride on organ toxicant concentrations and histopathology in rainbow trout, Oncorhynchus mykiss. Comp. Biochem. Physiol. Part C. Pharmacol. Toxicol. Endocrinol. 106(3), 717–724. Helmi, A.M., Mukti, A.T., Soegianto, A. and Effendi, M.H. 2020. A review of vibriosis in fisheries: public health importance. Sys. Rev. Pharm. 11(8), 51–58. Jorwal, P., Bharadwaj, S. and Jorwal, P. 2020. One health approach and Covid-19: aperspective. J. Fam. Med. Prim. Care. 9(12), 5888–5891. Madi, N.S., Elshrif, E.A., Elmarghani, A.M., Zweki, M.B., Elshewhdy, M.A. and Belkhair, S.S. 2006. Effect of untreated sewage discharge on the microbiological properties of seawater. Libyan. J. Marine. Sci. 14, 41–61. Madi, N.S., Elmarghani, A.M., Giddafi, M.H., Zweki, M.B. and Saad, M.T. 2015a. Detection of some human pathogenic bacteria in selected fresh fish sold in Tripoli city and its suburbs. Libyan. J. Marine Sci. 14, 14–15. Madi, N.S., Zweki, M.B., Elmarghani, A.M., Giddafi, M.H., Abuaissa, A.A., Elshewhdy, M.A., Elshrif, E.A., Abudaya, E.R. and Gerwash, E.M. 2015b. Incidence of human pathogenic Vibrio spp. in selected species of fresh fish. Libyan. J. Marine. Sci. 14, 32–36. Mohamad, N., Mustafa, M., Amal, M.N.A., Saad, M.Z., Md Yasin, I.S. and Al-saari, N. 2019. Environmental factors associated with the presence of Vibrionaceae in tropical cage-cultured marine fishes. J. Aquat. Anim. Health. 31(2), 154–167. Newton, A., Kendall, M., Vugia, D.J., Henao, O.L. and Mahon, B.E. 2012. Increasing rates of vibriosis in the United States, 1996–2010: review of surveillance data from 2 systems. Clin. Infect. Dis. 54(suppl_5), S391–S395. Osunla, C.A. and Okoh, A.I. 2017. Vibrio pathogens: a public health concern in rural water resources in Sub-Saharan Africa. Int. J. Environ. Res. Public Health. 14(10), 1188. Rahman, M., Sobur, M., Islam, M., Ievy, S., Hossain, M., El Zowalaty, M.E., Rahman, A. and Ashour, H.M. 2020. Zoonotic diseases: etiology, impact, and control. Microorganisms 8(9), 1405. Rehman, M.S.U., Rashid, N., Ashfaq, M., Saif, A., Ahmad, N. and Han, J.I. 2015. Global risk of pharmaceutical contamination from highly populated developing countries. Chemosphere 138, 1045–1055. Roux, F.L., Wegner, K.M., Baker-Austin, C., Vezzulli, L., Osorio, C.R., Amaro, C., Ritchie, J.M., Defoirdt, T., Destoumieux-Garzón, D. and Blokesch, M. 2015. The emergence of vibrio pathogens in Europe: ecology, evolution, and pathogenesis (paris, 11–12th March 2015). Front. Microbiol. 6, 830. Tan, C.W., Malcolm, T.T., Kuan, C.H., Thung, T.Y., Chang, W.S., Loo, Y.Y., Premarathne, J.M., Ramzi, O.B., Norshafawatie, M.F. and Yusralimuna, N. 2017. Prevalence and antimicrobial susceptibility of vibrio parahaemolyticus isolated from short mackerels (Rastrelliger brachysoma) in Malaysia. Front. Microbiol. 8, 1087. Tosun, Ş.Y., Alakavuk, D.Ü. and Mol, S. 2016. Isolation of Salmonella spp. and other members of Enterobacteriaceae from horse mackerel (Trachurus trachurus), sold in public markets of Istanbul, Turkey. Food. Health. 2(2), 82–89. Zutshi, B. and Prasad, S.R. 2008. Impact of pollution on fresh and marine water resources—a review. Poll. Res. 27(3), 461–466. | ||
| How to Cite this Article |
| Pubmed Style Bukha KK, Mahgiubi SAM, Elbahi AM, Sharif EA, Showehdi ML, Ahmed MO, Kammon AM, Abouzeed YM. Pathological lesions associated with Vibrio infection in Atlantic horse mackerel (Trachurus trachurus L., 1758) from the Western Coast of Tripoli, Libya. Open Vet. J.. 2023; 13(3): 327-336. doi:10.5455/OVJ.2023.v13.i3.9 Web Style Bukha KK, Mahgiubi SAM, Elbahi AM, Sharif EA, Showehdi ML, Ahmed MO, Kammon AM, Abouzeed YM. Pathological lesions associated with Vibrio infection in Atlantic horse mackerel (Trachurus trachurus L., 1758) from the Western Coast of Tripoli, Libya. https://www.openveterinaryjournal.com/?mno=64965 [Access: January 25, 2026]. doi:10.5455/OVJ.2023.v13.i3.9 AMA (American Medical Association) Style Bukha KK, Mahgiubi SAM, Elbahi AM, Sharif EA, Showehdi ML, Ahmed MO, Kammon AM, Abouzeed YM. Pathological lesions associated with Vibrio infection in Atlantic horse mackerel (Trachurus trachurus L., 1758) from the Western Coast of Tripoli, Libya. Open Vet. J.. 2023; 13(3): 327-336. doi:10.5455/OVJ.2023.v13.i3.9 Vancouver/ICMJE Style Bukha KK, Mahgiubi SAM, Elbahi AM, Sharif EA, Showehdi ML, Ahmed MO, Kammon AM, Abouzeed YM. Pathological lesions associated with Vibrio infection in Atlantic horse mackerel (Trachurus trachurus L., 1758) from the Western Coast of Tripoli, Libya. Open Vet. J.. (2023), [cited January 25, 2026]; 13(3): 327-336. doi:10.5455/OVJ.2023.v13.i3.9 Harvard Style Bukha, K. K., Mahgiubi, . S. A. M., Elbahi, . A. M., Sharif, . E. A., Showehdi, . M. L., Ahmed, . M. O., Kammon, . A. M. & Abouzeed, . Y. M. (2023) Pathological lesions associated with Vibrio infection in Atlantic horse mackerel (Trachurus trachurus L., 1758) from the Western Coast of Tripoli, Libya. Open Vet. J., 13 (3), 327-336. doi:10.5455/OVJ.2023.v13.i3.9 Turabian Style Bukha, Khawla K., Shaima A. M. Mahgiubi, Asma M. Elbahi, Ehab A. Sharif, Mohamed L. Showehdi, Mohamed O. Ahmed, Abdulwahab M. Kammon, and Yousef M. Abouzeed. 2023. Pathological lesions associated with Vibrio infection in Atlantic horse mackerel (Trachurus trachurus L., 1758) from the Western Coast of Tripoli, Libya. Open Veterinary Journal, 13 (3), 327-336. doi:10.5455/OVJ.2023.v13.i3.9 Chicago Style Bukha, Khawla K., Shaima A. M. Mahgiubi, Asma M. Elbahi, Ehab A. Sharif, Mohamed L. Showehdi, Mohamed O. Ahmed, Abdulwahab M. Kammon, and Yousef M. Abouzeed. "Pathological lesions associated with Vibrio infection in Atlantic horse mackerel (Trachurus trachurus L., 1758) from the Western Coast of Tripoli, Libya." Open Veterinary Journal 13 (2023), 327-336. doi:10.5455/OVJ.2023.v13.i3.9 MLA (The Modern Language Association) Style Bukha, Khawla K., Shaima A. M. Mahgiubi, Asma M. Elbahi, Ehab A. Sharif, Mohamed L. Showehdi, Mohamed O. Ahmed, Abdulwahab M. Kammon, and Yousef M. Abouzeed. "Pathological lesions associated with Vibrio infection in Atlantic horse mackerel (Trachurus trachurus L., 1758) from the Western Coast of Tripoli, Libya." Open Veterinary Journal 13.3 (2023), 327-336. Print. doi:10.5455/OVJ.2023.v13.i3.9 APA (American Psychological Association) Style Bukha, K. K., Mahgiubi, . S. A. M., Elbahi, . A. M., Sharif, . E. A., Showehdi, . M. L., Ahmed, . M. O., Kammon, . A. M. & Abouzeed, . Y. M. (2023) Pathological lesions associated with Vibrio infection in Atlantic horse mackerel (Trachurus trachurus L., 1758) from the Western Coast of Tripoli, Libya. Open Veterinary Journal, 13 (3), 327-336. doi:10.5455/OVJ.2023.v13.i3.9 |